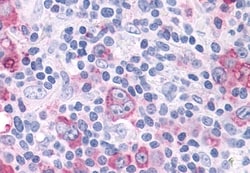
Invitrogen ROR gamma Polyclonal Antibody 50 &mu;g; Unconjugated:Antibodies,

missing translation for 'onlineSavingsMsg'
Learn More
Learn More
Invitrogen™ ROR gamma Polyclonal Antibody


Rabbit Polyclonal Antibody
Brand: Invitrogen™ PA534167
This item is not returnable.
View return policy
Description
Percent identity with other species by BLAST analysis: Human, Chimpanzee, Gorilla, Orangutan, Gibbon, Monkey, Marmoset, Tamarin, Elephant, Bat (100%).
ROR gamma is a 560 amino acid novel DNA-binding transcription factor belonging to the ROR/RZR orphan nuclear receptor subfamily. Reports suggest thatROR gammais a ligand activated transcription factor and may be essential for lymphoid organogenesis (lymph nodes and Peyer's patches) and may play an important regulatory role in controlling apoptosis during thymopoiesis. ROR gamma inhibits the expression of Fas ligand and IL2 and directs the differentiation program of proinflammatory IL-17+ T helper cells. ROR gamma shares 50 to 51% sequence identity with RORA and RORB and is 88% identical to mouse ROR gamma. It is highly expressed in skeletal muscle and at lower levels in various other tissues.
Specifications
| ROR gamma | |
| Polyclonal | |
| Unconjugated | |
| RORC | |
| IMD42; Nr1f3; Nuclear receptor ROR-gamma; nuclear receptor RZR-gamma; Nuclear receptor subfamily 1 group F member 3; RAR related orphan receptor C; RAR-related orphan nuclear receptor variant 2; RAR-related orphan receptor C; RAR-related orphan receptor C, isoform a; RAR-related orphan receptor gamma; retinoic acid-binding receptor gamma; retinoid-related orphan receptor gamma; retinoid-related orphan receptor-gamma; RORC; RORG; RORgamma; RZRG; RZR-GAMMA; Thor; Thymus orphan receptor; TOR | |
| Rabbit | |
| Antigen affinity chromatography | |
| RUO | |
| 6097 | |
| Store at 4°C short term. For long term storage, store at -20°C, avoiding freeze/thaw cycles. | |
| Liquid |
| Immunohistochemistry (Paraffin) | |
| 1 mg/mL | |
| PBS with 0.1% sodium azide | |
| P51449 | |
| RORC | |
| Synthetic 18 amino acid peptide from ligand-binding domain of human ROR Gamma. | |
| 50 μg | |
| Primary | |
| Human, Monkey, Bat | |
| Antibody | |
| IgG |
Product Content Correction
Your input is important to us. Please complete this form to provide feedback related to the content on this product.
Product Title
Spot an opportunity for improvement?Share a Content Correction